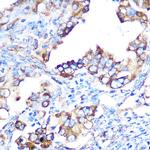
YBX1 Antibody in Immunohistochemistry (Paraffin) (IHC (P))

Search
Invitrogen
YBX1 Recombinant Rabbit Monoclonal Antibody (9J7M4)
{{$productOrderCtrl.translations['antibody.pdp.commerceCard.promotion.promotions']}}
{{$productOrderCtrl.translations['antibody.pdp.commerceCard.promotion.viewpromo']}}
{{$productOrderCtrl.translations['antibody.pdp.commerceCard.promotion.promocode']}}: {{promo.promoCode}} {{promo.promoTitle}} {{promo.promoDescription}}. {{$productOrderCtrl.translations['antibody.pdp.commerceCard.promotion.learnmore']}}
图: 1 / 11
YBX1 Antibody (MA5-42819) in ICC/IF

Please note: We are reviewing Western blot images included in the antibody testing data in our catalog, including those provided by third parties. Unless expressly labeled or annotated as “raw-unedited”, Western blot images included in the antibody testing data in our catalog may have been edited, optimized or otherwise adjusted for presentation.
产品信息
MA5-42819
种属反应
已发表种属
宿主/亚型
Expression System
分类
类型
克隆号
抗原
偶联物
形式
浓度
规格
纯化类型
保存液
内含物
保存条件
运输条件
RRID
产品详细信息
Positive test controls include: Mouse testis, Rat heart, HeLa. The target is usually found in the following locations: Cytoplasm, Cytoplasmic granule, Nucleus, Secreted.
Immunogen sequence: GAGEQGRPVR QNMYRGYRPR FRRGPPRQRQ PREDGNEEDK ENQGDETQGQ QPPQRRYRRN FNYRRRRPEN PKPQDGKETK AADPPAENSS APEAEQGGAE
靶标信息
YBX1 binds to splice sites in pre-mRNA and regulates splice site selection. This protein binds and stabilizes cytoplasmic mRNA and contributes to the regulation of translation by modulating the interaction between the mRNA and eukaryotic initiation factors. It binds to promoters that contain a Y-box (5'-CTGATTGGCCAA-3'), such as HLA class II genes. It regulates the transcription of numerous genes and promotes separation of DNA strands that contain mismatches or are modified by cisplatin. It has endonucleolytic activity and can introduce nicks or breaks into double-stranded DNA (in vitro), and it may play a role in DNA repair.
仅用于科研。不用于诊断过程。未经明确授权不得转售。
生物信息学
蛋白别名: BP8; CBF-A; CCAAT-binding; CCAAT-binding transcription factor 1 subunit A; CCAAT-binding transcription factor I subunit A; DBPB; DNA binding protein B; DNA-binding protein B; EFI-A; enhancer factor 1 alpha; enhancer factor 1 subunit A; Enhancer factor I subunit A; MDR NF1; MGC104858; MGC110976; MGC117250; nuclease sensitive element binding protein 1; Nuclease-sensitive element-binding protein 1; Y box transcription factor; Y-box binding protein 1; Y-box transcription factor; Y-box-binding protein 1; YB-1
基因别名: 1700102N10Rik; Byb1; C79409; Cbfa; Dbpb; EF1A; Msy-1; MSY1; mYB-1a; NSEP1; YB-1; YB1; YBX1
UniProt ID: (Mouse) P62960, (Rat) P62961
Entrez Gene ID: (Mouse) 22608, (Rat) 500538




